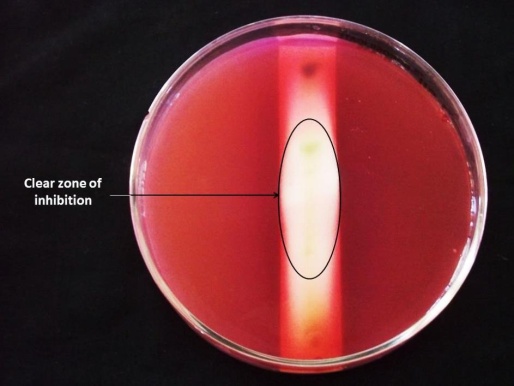

EVALUATION OF ANTIBACTERIAL AND ANTIFUNGAL ACTIVITY OF FENUGREEK (TRIGONELLA FOENUM-GRAECUM) EXTRACTS
DARSHAN DHARAJIYA1*, HITESH JASANI1, TARUN KHATRANI1, MANTHAN KAPURIA2, KAREN PACHCHIGAR1, PAYAL PATEL3
1Department of Plant Molecular Biology and Biotechnology, C. P. College of Agriculture, Sardarkrushinagar Dantiwada Agricultural University, Sardarkrushinagar 385506, Gujarat, India, 2Shree P. M. Patel Institute of Integrated M. Sc. in Biotechnology, Anand 388001, Gujarat, India, 3Ashok and Rita Patel Institute of Integrated Study and Research in Biotechnology and Allied Sciences (ARIBAS), New V. V. Nagar 388120, Gujarat, India
Email: darshanbiotech1@gmail.com
Received: 12 Jan 2016 Revised and Accepted: 18 Feb 2016
ABSTRACT
Objective: The present investigation was performed to evaluate the antimicrobial potential of Trigonella foenum-graecum leaves extracts and to elucidate the presence of phytochemicals responsible for its biological activity.
Methods: The plant extracts were prepared by sequential cold maceration method by using four solvents viz., hexane, ethyl acetate, methanol and distilled water. Antimicrobial activity of extracts was carried out by agar well diffusion method against four bacteria and five fungi. Minimum inhibitory concentration (MIC) of different extracts was determined using the broth dilution method. Thin layer chromatography (TLC), TLC bioautography and phytochemicals analysis were also performed.
Results: The antibacterial activity of T. foenum-graecum leaves extracts was found maximum on Serratia marcescens with a zone of inhibition (ZOI) of 12.33±0.57 mm by aqueous extract followed by inhibition of Bacillus cereus (ZOI = 11.50±0.50 mm) by the methanol extract. The range of MIC of different extracts recorded was 6.25 to 25 mg/ml. Results of the antifungal activity showed that methanol extract showed a maximum zone of inhibition against Trichoderma viridae(ZOI = 14.5±0.5 mm) followed by ethyl acetate extract (ZOI = 12.0±1.0 mm). The MIC value for methanol extract against T. viridae was 6.25 mg/ml. The result of TLC bioautography revealed that compounds eluted at Rf 0.58 and Rf 0.67 exhibited strong while compounds eluted at Rf 0.31 and Rf 0.37 showed moderate antibacterial activity against S. marcescens. Phytochemicals analysis indicated that methanol and aqueous extracts contain more phytochemicals as compared to hexane and ethyl acetate extracts.
Conclusion: The results obtained in this study clearly indicate that T. foenum-graecum leaves extracts to have a significant potential to be used as an antimicrobial agent due to the presence of different phytochemicals.
Keywords: Antimicrobial activity, Phytochemicals analysis, TLC bioautography, Minimum Inhibitory Concentration (MIC), Trigonella foenum-graecum
© 2016 The Authors. Published by Innovare Academic Sciences Pvt Ltd. This is an open access article under the CC BY license (http://creativecommons.org/licenses/by/4.0/)
INTRODUCTION
The problem of drug resistance in microbes is increasing day by day [1, 2]. Continuous and overuse of synthetic antibiotics often produce tolerance in human and create resistance in microbes for a particular antibiotic. Being synthetic antibiotics have a number of side effects over agents of natural origin. So, researchers strive to find out a drug that could be therapeutically efficacious towards a wide range of microorganisms with minimal or no side-effects [3]. The alarming increase in the rate of infectious diseases with antibiotic resistant microorganisms and side-effects of some synthetic antibiotics has led to an increasing interest towards medicinal plants as a natural alternative to synthetic drugs [4, 5].
In recent years, there has been a gradual revival of interest concerning the use of medicinal and aromatic plants in developed as well as in developing countries in utilization to develop antimicrobial drugs, because plant-derived drugs have been reported to be safe and without side-effects [6]. Traditionally the people of India have a long-standing practice of using a wide variety of herbal products in the treatment of diseases or as preservatives in foods. Spices are indispensable components of Indian cuisines since ancient times. Spices are considered as a rich source of bioactive antimicrobial compounds [7].
Trigonella foenum-graecum commonly known as fenugreek is an annual herb indigenous to the countries touching on the eastern shores of the Mediterranean and widely cultivated in India, Egypt, and Morocco [8]. The plant parts like leaves and seeds are widely consumed in Indo-Pak subcontinent as well as in other oriental countries as a spice in food preparations and as an ingredient in traditional medicines [9].A wide range of uses was found for fenugreek in ancient times. Fenugreek being rich in antioxidants and phytochemicals has been traditionally used as food, forage and medicinal plant [10, 11]. Medicinally it was used in the treatment of wounds, abscesses, arthritis, bronchitis, ulcer and digestive problems. Thus, fenugreek is food and a spice commonly eaten in many parts of the world for many years. Fenugreek is also used traditionally as a demulcent, laxative, lactation stimulant and exhibits hypocholesterolemic, hypolipidemic and hypoglycemic activity in healthy and diabetic animals and humans [9]. The pharmacological uses of different plant parts of fenugreek have been reported by different researchers. The seeds of fenugreek have been reported to have anti-diabetic [12, 13], anti-cancerous [14], anti-inflammatory [15] and antioxidant activity [16]. Its leaves have been reported to possess potential antibacterial activity [7, 17-20], antifungal activity [21], anti-diabetic [22] and antioxidant property [18, 23, 24]. Fenugreek is an ancient medicinal plant as the plant contains active constituents such as alkaloids, flavonoids, steroids, saponins, etc. [8].
The potential for developing antibacterial into medicine appears rewarding from both the perspective of drug development and the perspective of phytomedicine [25]. Most of the work regarding the antimicrobial activity of T. foenum-graecum was carried out using seeds as a plant material, but the use of leaves as a plant material was very limited. It is the first report for the evaluation of antimicrobial activity of T. foenum-graecum leaves against some microorganisms including two bacteria viz., Serratia marcescens and Bacillus cereus as well as all the fungal strains used in the present study. TLC bioautography of aqueous extract of T. foenum-graecum leaves against S. marcescens was also evaluated for the first time. Thus, to fulfil the aim of the present investigation, we evaluated the antimicrobial potential of Trigonella foenum-graecum leaves extracts and to elucidate the possible class of main components responsible for its biological activity.
MATERIALS AND METHODS
Plant material used in the study
Fenugreek (Trigonella foenum-graecum) plants were collected from local market of Anand, Gujarat, India. The taxonomic identities of these plants were confirmed by the taxonomist. Fresh plant materials (leaves) were washed with tap water followed by air drying and then homogenized to a fine powder. The powder was stored in airtight bottles at 4 °C.
Preparation of extracts
The extracts from plant leaves were prepared by sequential cold maceration method by utilizing four solvents viz., hexane, ethyl acetate, methanol and distilled water [26]. Fifty grams of dried powder of plant material was soaked in 250 ml hexane for 24 h at room temperature under shaking condition at 120 rpm. The mixture was filtered with whatman no. 1 filter paper. The filtrate was collected in Petri dishes and allowed the solvent to be evaporated at 37 °C. The dried extract was stored and further used for antimicrobial assay after dilution as per requirement. The filter cake was dried at room temperature and stored separately. The dried powder of filter cake was sequentially re-suspended in 250 ml ethyl acetate, methanol and distilled water to prepare dried extracts of plant material in each solvent. After extraction in each solvent, remaining filter cake was dried and further used with next solvent for extraction. All the extracts were concentrated to dryness and kept at 4 °C.
Preparation of sample from extract
To prepare the samples for the evaluation of antimicrobial activity, 100 mg of each extract were dissolved in 1 ml of dimethyl sulphoxide (DMSO).
Test microorganisms used in the study
Microorganisms were procured from the Department of Microbiology, ARIBAS, New V. V. Nagar, India. Out of four bacteria used in the study, three Gram-negative bacteria were Escherichia coli (MTCC No. 448), Pseudomonas aeruginosa (MTCC No. 424) and Serratia marcescens (local isolate) and a Gram-positive bacterium was Bacillus cereus (MTCC No. 135). All the bacterial strains used in the investigation were maintained at 4 °C on nutrient agar medium. All the test fungal strains, including Aspergillus niger, Aspergillus flavus,Aspergillus oryzae,Penicillium chrysogenumand Trichoderma viridaewere maintained at 4 °C on potato dextrose agar (PDA) slants.
Preparation of bacterial suspension
Colonies of different strains of bacteria (E. coli, S. marcescens, P. aeruginosa and B. cereus) were transferred to the different fresh nutrient broth in sterile conditions and were incubated at 37 °C for 24 h. These suspensions were preserved in 250 ml sterile flasks for further use.
Antibacterial activity
The antimicrobial activity of the test extracts was carried out by agar well diffusion method [26, 27]. For the antibacterial assay, initially, the stock cultures of bacteria were revived by inoculating in broth media and grown at 37 °C for 18 h. The plates of the Muller Hilton’s agar media were prepared. Each plate was inoculated with an aliquot (0.1 ml) of the bacterial suspension (105-106 colony forming unit “CFU”/ml) which was spread evenly on the surface of the medium of the plate. After 15 min, wells with 6 mm diameter were made with the help of a sterile cork borer in the solid medium and filled with the test samples of 100 mg/ml concentration. The positive and negative control wells were filled with Gentamicin (standard drug of 10 µg/ml concentration) and DMSO, respectively. All the plates were incubated at 37 °C for 24 h. The antibacterial activity was assessed by measuring the diameter of the zone of inhibition (ZOI) in mm. Triplicates were carried out for each extract against each of the test organism.
Antifungal activity
The antifungal activity the plant extracts was performed by agar well diffusion method [28]. For assessment of the antifungal activity of the extracts, the stock cultures of fungi were revived by inoculating in broth media and grown at 27 °C for 72 h. The plates of the potato dextrose agar (PDA) media were prepared. Each plate was inoculated with an aliquot (0.1 ml) of the fungal suspension (103spores/ml) which was spread evenly on the solid media. After 15 min, the wells with 6 mm diameter were made by using sterile cork borer and filled with test samples of 100 mg/ml concentration. The positive and negative control plates were also prepared with Fluconazole (standard drug of 10 mcg/disc concentration) and DMSO, respectively. All the plates were incubated at 27 °C for 5-7 d and then the diameter of the zone of inhibition was recorded. Triplicates were carried out for each extract against each of the test organism.
Determination of Activity Index (AI)
Activity index of all the extracts was calculated using following formula [26].
Determination of relative percentage inhibition (RPI)
The relative percentage inhibition of all the test extracts with respect to the positive control was calculated by using the following formula [26].

Where X= Total area of inhibition of the test extract; Y= Total area of inhibition of the solvent and Z= Total area of inhibition of the standard drug.
The total area of the inhibition was calculated by using the area = πr2; where r = radius of the zone of inhibition.
Determination of minimum inhibitory concentration (MIC)
Minimum inhibitory concentration of different extracts with respect to different bacteria and fungi was determined using broth dilution method [26]. Mueller-Hinton broth (HiMedia, Mumbai, India) was used only for the antibacterial study and potato dextrose broth (HiMedia, Mumbai, India) for the antifungal study. All the extracts dissolved in DMSO were first diluted to the highest concentration (100 mg/ml) to be tested and then two-fold serial dilution was made in the concentration range from 1.56 to 100 mg/ml. For broth dilution, 0.1 ml of standardized suspension of a strain (106 CFU/ml) separately was added to each tube containing various extracts at concentrations of 0 (control), 1.56, 3.125, 6.25, 12.5, 25, 50 and 100 mg/ml in broth medium. The tubes were incubated at 37 °C for 24 h for bacterial strains and 27 °C for 48 h for fungal strains and observed for visible growth after vortexing the tubes gently. The lowest concentration of extract in a tube that failed to show any visible growth was considered as the MIC. A tube containing nutrient broth and inoculum without extract was taken as a control. Bacterial and fungal suspensions were used as negative control while broth containing standard drugs was used as positive control.
Analytical thin layer chromatography (TLC)
Analytical TLC was performed to find out a suitable solvent system for the development of chromatogram. Different solvent systems were tried on pre-coated TLC plates (Merck, silica gel 60 F254 plate, 0.25 mm) to develop chromatogram. Among all, toluene: acetone: the glacial acetic acid (45:45:10) solvent system was found best and used for subsequent bioautography analysis. The components were visualized under visible light, and Rf values were recorded.
TLC Bioautography
The aqueous extract of T. foenum-graecum leaves was used for TLC bioautography against S. marcescens. Plates were developed with toluene: acetone: glacial acetic acid (45:45:10), which separated components into a wide range of Rf values. The components were visualized under visible light. Developed TLC plates were carefully dried for complete removal of the solvents and overlaid by nutrient agar seeded with an overnight culture of S. marcescens. The plate was incubated for 24 h at 37 °C and then sprayed with an aqueous solution of 5 mg/ml of methyl thiazol tetrazolium (Sigma). Inhibition zones were observed as clear spots against a purple background, and their Rf values were compared with the reference plate [29, 30].
Preliminary phytochemicals analysis
The extracts were tested for the presence of alkaloids, tannins, saponins, cardiac glycosides, steroids, phenols and flavonoids according to standard protocols for detecting the presence of different phytochemicals in the plant extracts [31].
RESULTS
Antibacterial activity
Antibacterial activity (in terms of the zone of inhibition, activity index and relative percentage inhibition) of the plant extracts was assessed against some selected pathogenic bacteria by agar well diffusion method. In the present study, total four extracts of T. foenum-graecum leaves having a concentration of 100 mg/ml were tested.
All the extracts showed antibacterial potential against test different bacteria. The inhibitory effect of T. foenum-graecum leaves extracts was found maximum on S. marcescens (ZOI = 12.33±0.57 mm and AI = 0.648) by aqueous extract followed by inhibition of Bacillus cereus (ZOI = 11.50±0.50 mm and AI = 0.761) by the methanol extract.
Hexane extract could only inhibit the growth of S. marcescens. While ethyl acetate extract showed a zone of inhibition against B. cereus. Methanol and aqueous extracts showed significant antimicrobial activity against all the test bacteria used in the study. P. aeruginosa was found most resistant bacteria which were slightly inhibited by methanol and aqueous extracts. The detailed result of the zone of inhibition for the antibacterial assay is represented in table 1 and results of the activity index along with the relative percentage inhibition are given in table 2.
MIC values of different extracts with respect to different bacteria were determined using a broth dilution method (table 3). Extracts showing antibacterial activity in agar well diffusion assay were further evaluated for determination of MIC values. The range of MIC of different extracts recorded was 6.25 to 25 mg/ml. In the present study, 6.25 mg/ml was recorded as the MIC for aqueous extract against S. marcescens. MIC for hexane and ethyl acetate was 25 mg/ml while MIC for methanol extract was 12.5 mg/ml against the most sensitive bacteria.
Table 1: Antibacterial activity (ZOI) of T. foenum-graecum leaves extracts
Extract |
Conc. (mg/ml) |
Bacterial strains and zone of inhibition (mm) |
|||
S. marcescens |
B. cereus |
P. aeruginosa |
E. coli |
||
Hexane |
100 |
9.66±0.57 |
- |
- |
- |
Ethyl Acetate |
100 |
- |
10.33±0.57 |
- |
- |
Methanol |
100 |
10.00±1.00 |
11.50±0.50 |
9.50±0.50 |
9.33±0.57 |
Aqueous |
100 |
12.33±0.57 |
11.33±1.15 |
9.33±0.57 |
10.50±0.50 |
Gentamicin |
10 µg/ml |
19.00±1.00 |
15.10±0.76 |
15.00±1.00 |
18.10±1.04 |
DMSO |
- |
- |
- |
- |
- |
(-): No zone of inhibition, DMSO: Dimethyl sulphoxide, ZOI: Zone of inhibition (including 6 mm well diameter), The test was done in triplicate, Diameter of the zone of inhibitions is given here as mean±standard deviation
Table 2: Antibacterial activity (AI and RPI) of T. foenum-graecum leaves extracts
Extract |
Conc. (mg/ml) |
S. marcescens |
B. cereus |
P. aeruginosa |
E. coli |
||||
AI |
RPI |
AI |
RPI |
AI |
RPI |
AI |
RPI |
||
Hexane |
100 |
0.508 |
25.84 |
- |
- |
- |
- |
- |
- |
Ethyl Acetate |
100 |
- |
- |
0.684 |
46.40 |
- |
- |
- |
- |
Methanol |
100 |
0.526 |
27.70 |
0.761 |
58.00 |
0.633 |
40.11 |
0.515 |
26.57 |
Aqueous |
100 |
0.648 |
42.11 |
0.750 |
56.30 |
0.622 |
38.68 |
0.580 |
33.65 |
AI: Activity Index, RPI: Relative Percentage Inhibition, (-): No inhibitory activity
Table 3: Minimum inhibitory concentration (MIC) of T. foenum-graecum leaves extracts against bacteria
Test organism |
MIC in mg/ml |
|||
Hexane |
Ethyl Acetate |
Methanol |
Aqueous |
|
Serratia marcescens |
25.0 |
NA |
25.0 |
6.25 |
Bacillus cereus |
NA |
25.0 |
12.5 |
25.0 |
Pseudomonas aeruginosa |
NA |
NA |
25.0 |
25.0 |
Escherichia coli |
NA |
NA |
25.0 |
12.5 |
MIC: minimum inhibitory concentration (mg/ml), NA: not assessed
Antifungal activity
Antifungal activity (in terms of zone of inhibition, activity index and relative percentage inhibition) of different extracts was evaluated against some fungi by agar well diffusion method. Results of the investigation showed that methanol extract of T. foenum-graecum leaves was able to give a maximum zone of inhibition against T. viridae (ZOI = 14.5±0.5 mm and AI = 0.649) followed by ethyl acetate extract (ZOI = 12.0±1.0 mm and AI = 0.537). Hexane and aqueous extracts slightly inhibited T. viridae. Growth of A. niger (ZOI = 10.33±0.57 mm and AI = 0.639) and A. flavus (ZOI = 9.16±0.28 mm and AI = 0.429) were inhibited by only hexane extract of T. foenum-graecum leaves whereas other extracts failed to give a zone of inhibition. A. oryzae was sensitive to only ethyl acetate extract while it was resistant to other three extracts. All the extracts of T. foenum-graecum leaves used in the study were failed to give any inhibitory effect against P. chrysogenum. The detailed result of the zone of inhibition for antibacterial assay is represented in table 4 and results of the activity index along with the relative percentage inhibition are given in table 5.
Table 4: Antifungal activity (ZOI) of T. foenum-graecum leaves extracts
Extract |
Conc. (mg/ml) |
Fungal strains and zone of inhibition (mm) |
||||
A. niger |
A. flavus |
A. oryzae |
P. chrysogenum |
T. viridae |
||
Hexane |
100 |
10.33±0.57 |
9.16±0.28 |
- |
- |
9.33±0.57 |
Ethyl Acetate |
100 |
- |
- |
8.33±0.57 |
- |
12.0±1.00 |
Methanol |
100 |
- |
- |
- |
- |
14.5±0.50 |
Aqueous |
100 |
- |
- |
- |
- |
9.66±0.57 |
Fluconazole |
10 mcg/disc |
16.16±1.04 |
21.33±1.15 |
16.00±1.00 |
18.66±1.52 |
22.33±0.57 |
DMSO |
- |
- |
- |
- |
- |
- |
(-): No zone of inhibition, DMSO: Dimethyl sulphoxide, Zone of inhibition including 6 mm well diameter, The test was done in triplicate, Diameter of the zone of inhibitions is given here as mean±standard deviation.
Table 5: Antifungal activity (AI and RPI) of T. foenum-graecum leaves extracts
Extract |
Conc. (mg/ml) |
A. niger |
A. flavus |
A. oryzae |
P. chrysogenum |
T. viridae |
|||||
AI |
RPI |
AI |
RPI |
AI |
RPI |
AI |
RPI |
AI |
RPI |
||
Hexane |
100 |
0.639 |
40.86 |
0.429 |
18.44 |
- |
- |
- |
- |
0.417 |
17.45 |
Ethyl Acetate |
100 |
- |
- |
- |
- |
0.520 |
27.10 |
- |
- |
0.537 |
28.87 |
Methanol |
100 |
- |
- |
- |
- |
- |
- |
- |
- |
0.649 |
42.16 |
Aqueous |
100 |
- |
- |
- |
- |
- |
- |
- |
- |
0.432 |
18.71 |
AI: Activity Index, RPI: Relative Percentage Inhibition, (-): No inhibitory activity
MIC values of different extracts with respect to different fungi were determined using broth dilution method. Extracts showing antifungal activity in agar well diffusion assay were further evaluated for MIC values. The MIC value for methanol extract against T. viridae was 6.25 mg/ml followed ethyl acetate extract having 12.5 mg/ml and against the same fungus. Hexane and aqueous extracts have MIC value of 50 mg/ml against T. viridae. MIC of hexane extract was 50 mg/ml against A. niger and 100 mg/ml against A. flavus. The results of MIC values determination are shown in table 6.
Table 6: MIC of T. foenum-graecum leaves extracts against fungi
Test organism |
MIC in mg/ml |
|||
Hexane |
Ethyl acetate |
Methanol |
Aqueous |
|
A. niger |
50.0 |
NA |
NA |
NA |
A. flavus |
100 |
NA |
NA |
NA |
A. oryzae |
NA |
100 |
NA |
NA |
P. chrysogenum |
NA |
NA |
NA |
NA |
T. viridae |
50.0 |
12.5 |
6.25 |
50.0 |
MIC: minimum inhibitory concentration (mg/ml), NA: not assessed
Analytical TLC and TLC bioautography
The Rf values and colour of bands of the aqueous extract of T. foenum-graecum leaves separated by TLC have been summarized in table 7. TLC bioautography assay allowed outlining the chemical profile of the aqueous extract thus detecting the active substances having antimicrobial activity. The result of this assay revealed that compounds eluted at Rf 0.58 and Rf 0.67 exhibited strong while compounds eluted at Rf 0.31 and Rf 0.37 showed moderate antibacterial activity against S. marcescens, suggesting thereby the presence of antimicrobial active substances (fig. 1).
Phytochemical analysis
The qualitative phytochemicals analysis is useful in determining the presence of significant chemical constituents of the extracts. The results of preliminary analysis of phytochemicals are given in table 8. Results indicated that methanol and aqueous extracts contain more phytochemicals as compared to hexane and ethyl acetate extracts.
Fig. 1: TLC bioautography of aqueous extract of T. foenum-graecum leaves against S. marcescens
Table 7: Rf value and colour of band of the aqueous extract of T. foenum-graecum leaves separated by Thin Layer Chromatography (TLC)
Rf value |
Band colour in visible light |
0.31 |
Greenish yellow |
0.37 |
Yellow |
0.58 |
Light green |
0.67 |
Light green |
0.86 |
Green |
0.93 |
Dark green |
Table 8: Qualitative analysis for phytochemicals present in various extracts of T. foenum-graecum leaves
Name of phytochemical |
Extracts |
|||
Hexane |
Ethyl acetate |
Methanol |
Aqueous |
|
Alkaloids |
+ |
+ |
+ |
+ |
Saponins |
+ |
+ |
+ |
+ |
Tannins |
− |
− |
+ |
− |
Sterols |
− |
+ |
+ |
+ |
Cardiac glycoside |
+ |
+ |
+ |
+ |
Flavanoids |
− |
− |
− |
+ |
Phenol |
+ |
− |
+ |
+ |
(+): Present, (-): Absence
DISCUSSION
Infectious diseases are the main cause of mortality worldwide. The number of multidrug-resistant microbial strains and strains with reduced susceptibility to antibiotics are continuously increasing due to indiscriminate use of antibiotics and other synthetic antibacterial agents in treatment [31, 32].
Plants have been used for medicinal purposes and are the primary source of phytochemicals present in conventional medicaments since the existence of human being. The relationships between cultures and the traditional use of plants have been described by various Ethnobotanical studies. These studies are of the utmost importance and provide essential information that allows the development of scientific research more oriented to explore and prove the therapeutic potential of plants [33]. Plants used in traditional medicine contain a vast array of substances that can be utilized to treat chronic and even infectious diseases. More than 80% of world’s populations depend on traditional medicines derived from plants for their primary health care needs [43]. The plant-based traditional medicines were proven highly effective for their utilization as a source of antimicrobial compounds [32]. Plants are rich in a wide variety of secondary metabolites such as terpenoid, tannins, alkaloids, and flavonoids, which have been found to have medicinal properties [20].
Agar well diffusion techniques have been widely utilized to assay the antimicrobial activity of plant extracts [7, 26, 31, 33]. In the present study, we found that aqueous and methanol extracts ofT. foenum-graecum leaves possess higher antibacterial activity. One of the very few previous studies on the antimicrobial activity of T. foenum-graecum also showed that methanol extract of fenugreek has antibacterial activity against Pseudomonas sp., E. coli, Shigella dysenteries and Salmonella typhi [7]. In another study, high antimicrobial activity against peptic ulcer-linked Helicobacter pylori was found in the fenugreek sprout extract [18]. It was reported that the inhibitory effects of T. foenum-graecum on Escherichia coli and Klebsiella pneumonia were only with the aqueous fraction. Whereas, crude extract, petroleum ether, and dichloromethane fractions did not show any inhibitory effect [19]. T. foenum-graecum also displayed antibacterial activity against Bacillus subtilis, Sarcina lutea, Xanthomonas campestris, Proteus vulgaris and Pseudomonas denitrificans [20]. Thus, present and previous studies lead us to conclude that methanol and aqueous extracts have maximum inhibitory action on different bacterial strains.According to a previous report, the MIC values of acetone extract were found to be 64 µg/ml against Shigella dysentiriae and Pseudomonas sp. The MIC value was found 16 µg/ml against E. coli [7]. The range of MIC was found to be between 1.25 and 80 μg/μl. Most of the test microorganisms were inhibited by 80 and 40 μg/μl of the crude extracts of T. foenum-graecum. [19]. Hence, T. foenum-graecum showed a great potential of antibacterial activity against gram positive and gram negative bacteria.
Results of the present investigation showed that all the extracts of T. foenum-graecum leaves inhibit the growth of T. viridae and failed to prevent the growth of P. chrysogenum. The growth of A. niger, A. oryzae and A. flavus was inhibited by an only single extract of T. foenum-graecum leaves. Methanol extract possessed the most effective antifungal activity in the present study. Results of a previous study suggested that the constituents of T. foenum-graecum have potential against harmful pathogenic fungi viz., Fusariumgraminearum, Alternaria sp. and Rhizoctinia solani [21]. The same study indicated that the antifungal activity of T. foenum-graecum resided mainly in the methanol fraction. The minimum inhibitory concentration (MIC) of methanol fraction which caused total inhibition of Rhizoctonia solani and Alternaria sp. was found to be 60 μg/ml [21]. Therefore, T. foenum-graecum could be an important source of biologically active compounds useful for developing better new antifungal drugs.
Based on the results of the antibacterial assay and TLC bioautography, it is concluded that T. foenum-graecum have a stronger antibacterial activity against bacteria tested in the present study. Further work can be done to isolate and identify antimicrobial substances present in the extracts to prepare highly competent antimicrobial drugs.
Results of the present study suggested that methanol and aqueous extracts contain more phytochemicals as compared to hexane and ethyl acetate extracts. Almost similar results were found in past work for the qualitative analysis of fenugreek seeds for the presence of phytochemicals in different extracts [35]. The knowledge of the extent and mode of action for antifungal activity of specific compounds, present in the plant extracts, may lead to the successful utilization of such natural compounds for the treatment of infections caused by pathogenic microorganisms. Further identification and purification of active chemical constituents from the crude plant extracts will be helpful to develop drugs against pathogenic microorganisms.
CONCLUSION
From the present study, it is concluded that a potent antimicrobial activity against various pathogenic microorganisms by T. foenum-graecum leaves extracts especially methanol and aqueous extracts. Natural substances which are part of daily diet nutritional supplement with antimicrobial property constitute a new source of herbal drugs. The antimicrobial potential of this plant is a remarkable relevance as T. foenum-graecum leaves are edible and generally consumed and no extra processing is needed for its administration. Further isolation and exploration on the isolated chemical constituents on antimicrobial activity may lead to chemical entities for clinical application.
CONFLICT OF INTERESTS
Declare none
REFERENCES
- Teshager T, Herrero IA, Porrero MC, Garde J, Moreno MA, Domı́nguez L. Surveillance of antimicrobial resistance in Escherichia coli strains isolated from pigs at Spanish slaughterhouses. Int J Antimicrob Agents2000;15:137-42.
- Cohen ML. Changing patterns of infectious disease. Nature 2000;406:762-7.
- Shrikanth VM, Janardhan B, Dhananjaya BL, Muddapura UM, More SS. Antimicrobial and antioxidant activity of methanolic root extract of Tabernaemontana alternifolia L. Int J Pharm Pharm Sci 2015;7:66-9.
- Raghunath D. Emerging antibiotic resistance in bacteria with special reference to India. J Biosci 2008;33:593-603.
- Dhayalan M, Jegadeeshwari A, Gandhi N. Biological activity sources from traditionally used tribe and herbal plants material. Asian J Pharm Clin Res 2015;8:11-23.
- Rai M, Acharya D, Wadegaonkar P. Plant derived-antimycotics; potential of Asteraceous plants. Plant-derived antimycotics. Current trends and future prospects. Hartworth Press. NY; 2003. p. 165-95.
- Dash BK, Sultana S, Sultana N. Antibacterial activities of methanol and acetone extracts of fenugreek (Trigonella foenum) and coriander (Coriandrum sativum). Life Sci Med Res 2011;27:1-8.
- Snehlata HS, Payal DR. Fenugreek (Trigonella foenum-graecum L.): an overview. Int J Curr Pharm Rev Res 2012;2:169-87.
- Syeda BB, Muhammad IB, Shahabuddin M. Antioxidant activity from the extract of fenugreek seeds. Pak J Anal Environ Chem 2008;9:78-83.
- Petropoulos GA. Fenugreek-The genus Trigonella, Taylor and Francis, London and New York; 2002.
- Basch E, Ulbricht C, Kuo G, Szapary P, Smith M. Therapeutic applications of fenugreek. Altern Med Rev 2003;8:20-7.
- Xue WL, Li XS, Zhang J, Liu YH, Wang ZL, Zhang RJ. Effect of Trigonella foenum-graecum (fenugreek) extracts on blood glucose, blood lipid and hemorheological properties in streptozotocin-induced diabetic rats. Asia Pac J Clin Nutr 2007;16(Suppl 1):422-6.
- Karim A, Sohail MN, Munir S, Sattar S. Pharmacology and phytochemistry of Pakistani herbs and herbal drugs used for the treatment of diabetes. Int J Pharmacol 2011;7:419-39.
- Shabbeer S, Sobolewski M, Anchoori RK, Kachhap S, Hidalgo M, Jimeno A, et al. Fenugreek: a naturally occurring edible spice as an anticancer agent. Cancer Biol Ther 2009;8:272-8.
- Subhashini N, Nagarajan G, Kavimani S. Anti-inflammatory and in vitro antioxidant property of Trigonella foenum graecum seeds. J Pharmacol Toxicol 2011;6:371-80.
- Kaviarasan S, Naik GH, Gangabhagirathi R, Anuradha CV, Priyadarsini KI. In vitro studies on antiradical and antioxidant activities of fenugreek (Trigonella foenum graecum) seeds. Food Chem 2007;103:31-7.
- Yasmin H, Kaisar MA, Sarker MMR, Rahman MS, Rashid MA. The preliminary anti-bacterial activity of some indigenous plants of Bangladesh. Dhaka Univ J Pharm Sci 2009;8:61-5.
- Randhir R, Lin YT, Shetty K. Phenolics, their antioxidant and antimicrobial activity in dark germinated fenugreek sprouts in response to peptide and phytochemical elicitors. Asia Pac J Clin Nutr 2004;13:295-307.
- Abdel-Massih R, Abdou E, Baydoun E, Daoud Z. Antibacterial activity of the extracts obtained from Rosmarinus officinalis, Origanum majorana, and Trigonella foenum-graecum on highly drug-resistant gram-negative bacilli. J Bot 2010. Doi.org/ 10.1155/2010/464087. [Article in Press]
- Nahar N, Rahman MS, Rahman SM, Moniruzzaman M. GC-MS analysis and antibacterial activity of Trigonella foenum-graecum against bacterial pathogens. Free Radicals Antioxid 2016;6:109-14.
- Haouala R, Hawala S, El-Ayeb A, Khanfir R, Boughanmi N. Aqueous and organic extracts of Trigonella foenum-graecum L. inhibit the mycelia growth of fungi. J Environ Sci 2008;20:1453-7.
- Mitra A, Bhattacharya D. Dose-dependent effects of Fenugreek composite in Diabetes with dislipidaemia. Internet J Food Safety 2006;8:49-55.
- Gowda TSS, Dinesha R, Harsha R, Leela S. Free radical scavenging activity of lutein–isolated from methi leaves (Trigonella foenum graecum). Int J Pharm Pharm Sci 2010;2:113-7.
- Mandal P, Gupta SK. Improvement of antioxidant activity and related compounds in fenugreek sprouts through nitric oxide priming. Int J Pharm Sci Rev Res 2014;26:249-57.
- Rahman A, Parvez MAK, Parvin T, Paul DK, Sattar MA. Antimicrobial activity of three bioactive compounds from the stream bark of Piper chaba hunter. Biosci Res 2004;1:16-20.
- Dharajiya D, Patel P, Patel M, Moitra N. In vitro antimicrobial activity and qualitative phytochemical analysis of Withania somnifera (L.) Dunal extracts. Int J Pharm Sci Rev Res 2014;27:349-54.
- Thakur S, Tiwari KL, Jadhav SK. Antibacterial screening of root extract of Asparagus racemosus Willd. Curr Trends Biotechnol Pharm 2015;9:147-50.
- Dharajiya D, Khatrani T, Patel P, Moitra N. Evaluation of antifungal activity of Emblica officinalis, Aloe vera and Vitex negundo extracts. J Chem Biol Phys Sci 2015;5:3990-6.
- Gupta PC, Batra R, Chauhan A, Goyal P, Kaushik P. Antibacterial activity and TLC bioautography of Ocimum basilicum L. against pathogenic bacteria. J Pharm Res2009;2:407-9.
- Ishnava KB, Chauhan JB, Garg AA, Thakkar AM. Antibacterial and phytochemical studies on Calotropis gigantia (L.) R. Br. latex against selected cariogenic bacteria. Saudi J Biol Sci 2012;19:87-91.
- Dharajiya D, Patel P, Moitra N. Antibacterial activity of Emblica officinalis (Gaertn.) Fruits and Vitex negundo (L.) Leaves. Curr Trends Biotechnol Pharm 2015;9:357-68.
- Iwu MW, Duncan AR, Okunji CO. New antimicrobials of plant origin. Perspectives on new crops and new uses. Alexandria, VA: ASHS Press; 1999. p. 457-62.
- Martins S, Amorim EL, Sobrinho TJP, Saraiva AM, Pisciottano MN, Aguilar CN, et al. Antibacterial activity of crude methanolic extract and fractions obtained from Larrea tridentata leaves. Ind Crops Prod 2013;41:306-11.
- Duraipandiyan V, Ayyanar M, Ignacimuthu S. Antimicrobial activity of some ethnomedicinal plants used by a paliyar tribe from Tamil Nadu, India. BMC Complementary Altern Med 2006;6:35.
- Yadav R, Tiwari R, Chowdhary P, Pradhan CK. A pharmacognostical monograph of Trigonella foenum-graecum seeds. Int J Pharm Pharm Sci 2011;3:442-5.